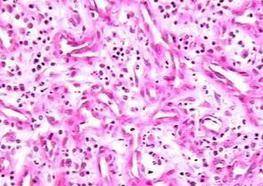
脐窝内有肉芽组织增生

脐窝内有肉芽组织增生
的有关信息介绍如下:
脐窝内有肉芽组织增生是断脐后未愈合的伤口受异物的刺激或经常摩擦而形成的息肉样、樱红色小肉芽肿,呈米粒至黄豆大小,有脓血性分泌物,不易痊愈。过多的肉芽组织可用10%硝酸银腐蚀或用消毒剪刀去除,保持局部清洁,很快就能痊愈。脐窝内有肉芽组织增生 是脐带脱落后出现的一种组织增生,也可能是由于肠管与肚脐相连、黏膜鼓起导致的。脐肉芽肿非常容易造成感染,引起炎症,是需立即就医处理的脐部疾病。
想要了解更多“脐窝内有肉芽组织增生”的信息,请点击:脐窝内有肉芽组织增生百科



